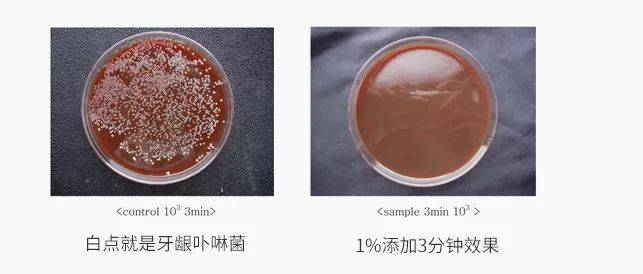

得过韩国大奖的抗幽门螺杆菌牙膏,可吞咽更安心
中国经营报
原标题:得过韩国大奖的抗幽门螺杆菌牙膏,可吞咽更安心
物质条件越发富足,饮食习惯却越来越差
尤其在餐馆吃饭,真是生冷不忌
食品卫生状况堪忧
这不仅增加了肠胃的负担
也给了病菌可乘之机,病从口入不得不防!

细菌病毒随着食物进入口腔,直达肠胃
不光在口腔中搞事情(口臭、牙周炎)
更是会百般折腾我们的胃肠道
10个现代人8个都有不同程度的胃痛
一旦发展成严重的胃病,后悔都来不及!

如何用最小的改变解决这个头疼的问题?
果小妞推荐给大家一款具有神奇功效的
麦斯特凯斯乳香牙膏
每天只需刷牙3分钟
就可以对抗口腔中的幽门螺旋杆菌
(导致胃病的最大元凶就是它!🤧)
点击图片,即可购买小编推荐理由:
1
对抗胃病第一大致病菌“幽门螺旋杆菌”:来自欧盟PDO原产地认证的珍贵乳香,抑菌效果是蜂胶的15.6倍!
2
学术界认可,降低胃病复发率:全美十大癌症专家巴巴拉博士强烈推荐乳香~日本静冈县立大学也证实了它神奇的功效。
3
去除口臭,改善胀气打嗝:抑制口臭菌,改善牙周炎,口气越来越清新~

幽门螺杆菌癌变率远超普通人
用它刷牙就可有效预防胃病
胃酸都杀不死的致癌细菌
普通的细菌通过口腔进入人体,最多让你闹个肚子,但是过两天也就消停了。
唯独一种叫做“幽门螺杆菌”的细菌,一旦从口腔偷溜进胃部,连胃酸(强酸啊!!😈)都杀不死它!

它会让年轻人感染胃溃疡,疼到你们痛不欲生。如果感染了体弱的老年人,甚至会提高胃癌的风险!

2017年10月27日,世界卫生组织国际癌症研究机构公布的《120种一类致癌物清单》中,幽门螺杆菌排在第54位。

专业医学报告更提出幽门螺杆菌感染者的癌变概率,远远高于普通人!

※资料来源《第五次全国幽门螺杆菌感染处理共识报告》
(中国消化杂志,2017,37(6) : 364-378)
一人感染 全家得病
幽门螺杆菌的可怕之处在于:人与人之间的传染性非常强。

※资料来源《口腔幽门螺杆菌的研究进展》
(河南医学研究,2013,22(2) : 312-315)
家人共餐、日常亲吻、喂孩子,与朋友、同事一起刷个火锅,都有可能中招!

特别是儿童幽门螺杆菌感染者(主要来自父母等家庭成员的传染)。

潜在胃癌人群 中国感染者已超7亿
数据显示,在中国,感染幽门螺杆菌的人数已超7亿,2个人里面差不多就有1个人!

毫不夸张的说,你可能就是幽门螺杆菌的潜在患者!
感染人数如此庞大,也难怪我国胃癌高发,
每年胃癌发病人数占全球的42%,高居全球首位!

欧盟PDO认证的珍贵乳香
对幽门菌有明显抑制作用
珍贵的天然乳香 多国药典收录
而韩国麦斯特凯斯乳香牙膏,里面2%乳香,则是幽门菌的强大的对手。

乳香,是从乳香黄连木中采取的树胶提取物,希腊人很早就发现乳香有益健康。

它也被全球多个国家的药典收录,包括英国药典(BP)、欧洲药典(EP)、中国药典(ChP)等。

牙膏中添加的精品乳香来自希腊爱琴海希俄斯(CHIOS)岛,每年产出的数量十分稀少,抑菌功效更强。

它不仅取得了垄断供应权,还获得欧盟PDO原产地认证。

大家都知道幽门螺杆菌的治疗更多采用抗生素。但是抗生素容易引发过敏,还有耐药性和各种副作用。

但乳香作为纯天然的成分,科学证实它对幽门螺杆菌有良好的抑制效果。
且孕妇、儿童、哺乳期女性等特殊人群也可以使用!

学术专家推荐 高校研究院认可
乳香对抗幽门螺杆菌的作用也获得了国内外的广泛认可。
人为什么闻不出自己有口臭?
👆美国癌症预防专家特别推荐乳香!
新英格兰时报1998年12月24日发表文章,
证实乳香对幽门螺杆菌有抑制作用。

日本静冈县立大学在其研究报告中证实了乳香对幽门螺杆菌的抑制作用

韩国生物科学与生物技术研究院的试验,把乳香添加到幽门螺杆菌培养液里,可以看到
乳香对幽门螺杆菌明显的抑制作用。

韩国麦斯特凯斯乳香牙膏中,含有2%希俄斯岛乳香成分,能够对抗口腔中的幽门螺杆菌,减小幽门螺杆菌口腔传播的可能!

降低幽门螺杆菌复发率
对于已经感染上幽门螺杆菌的人群,如果你们的胃病总是反反复复..

很可能是因为忽视了口腔的清洁,才导致隐藏在牙菌斑里的幽门螺杆菌再一次偷偷溜回胃里!

因此治疗幽门螺杆菌最好的方式就是四联疗法配合乳香牙膏,清除口腔细菌,才能减少复发的几率!

口气更清新 牙齿越刷越亮白
抑制口臭菌 口气越来越清新
国际知名医学杂志《JAMA》刊登过口臭专刊,文中指出,大约90%的口臭源自口腔细菌。

乳香的强大之处,在于它不仅仅能抑制幽门螺杆菌,对口腔中的很多其他细菌都有抑制作用。

《乳香提取物对两种牙周致病菌体外抑菌作用的研究》
中老年口腔医学杂志 2017(第15卷 第4期 ):224-227
韩国生物科学与生物技术研究院的试验中,在口臭、牙周炎的重要致病菌牙龈卟啉单胞菌的培养液里投放乳香后,可以看到牙龈卟啉单胞菌被明显抑制。
每天使用麦斯特凯斯乳香牙膏,口腔不再有异味,刷牙后的嘴里,还有一种丝丝的松柏香料味道。

口气清新舒爽,想要亲女朋友,也不会被嫌弃了,甜甜蜜蜜,想亲就亲~

细菌拜拜 健康牙齿又亮又白
一支不能洁白牙齿的牙膏是没有灵魂的,麦斯特凯斯乳香牙膏,加入了与牙齿相同的成分,即羟基磷灰石(HAP)粒子。

HAP粒子与牙釉质有着良好的生物亲和性,在清除牙渍的同时,在牙齿表面自然形成一层保护层。

保护层将食用色素阻挡在牙齿之外,避免吸附沉积。
再也不用担心抽烟、喝茶、咖啡、可乐让我们牙齿变黄了,让牙齿展现出原本釉质的洁白光亮。

膏体沾水之后,泡沫细腻,深入清洁口腔的每一个角落,清洁牙齿缝隙,轻松带走食物残渣,呵护牙齿健康。牙齿变的又白又亮~

好评如潮 上来就卖断货
韩国麦斯特凯斯乳香牙膏,
刚一登陆中国市场,
就遭到了疯抢,
短期内各个渠道都卖!断!货!
收获了一大批忠实粉丝,
来秀一波好评,就是这么霸气。

能对抗幽门螺杆菌的韩国进口乳香牙膏
现在福利大放送!
麦斯特凯斯乳香牙膏
数量有限 快快抢购吧